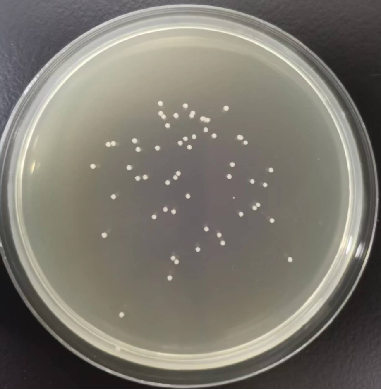

产品介绍
COD去除菌剂ZG-1200是由经过筛选的高效好氧菌和兼性厌氧菌组成,能够有效降解天然和合成的有机污染物。对石化、化工、煤化工、钢铁、纺织、制药等行业难降解有机污染物的去除具有良好的效果。
产品适用
COD去除菌剂ZG-1200主要应用于石化、造纸、煤化工、钢铁、纺织、制药等行业工业废水的生化处理系统。这些污水处理系统会接收大量的有机物,其中一些是有毒、难降解的。这些有机物进入系统,容易造成系统运行不稳,出水超标,增加运行成本。COD去除菌剂ZG-1200含有的特效微生物菌种,能够增强生物降解能力,提高系统COD去除率。在预防性维护阶段,该产品可以强化废水处理系统运行效果,提高系统稳定性,降低成本。
产品特性
| 外观形态 | 固体粉末 |
|---|---|
| 内含物 | 微生物菌种等 |
| 菌落总数 | ≥8×1010 CFU/g |
| 保质期 | 1年 |
| 包装 | 10kg/桶 |
使用方法
通常,COD去除菌剂ZG-1200直接投加到污水处理系统曝气池内,平均投加量在15-20ppm/天之间。如有需要,可以联系我司技术人员为您制定适合的、详细的技术方案。
最佳使用条件
为了达到最佳使用效果,建议在以下条件范围使用产品:
| 条件 | 范围 | 最佳值 |
|---|---|---|
| DO,mg/L | 2.0~4.0 | 2.5 |
| pH | 6~9 | 7 |
| 温度,℃ | 10~40 | 35 |
| 毒性重金属,mg/L | 微量 | 无 |
| 营养 BOD:NH3-NBOD:PO43--P | 10:(0.5~1)100:(0.5~1) | 10 : 1100 : 1 |
如果系统运行条件在上述条件范围之外,请联系我司,寻求全面的系统调查和建议。
储存和操作
| 储存 | 4℃~35℃,干燥环境,无需冷藏。使用之前禁止打开包装,防止受潮。 |
|---|---|
| 操作 | 注意:避免吸入干燥粉末或液体的挥发性物质。避免皮肤接触干燥粉末或浓溶液。如果接触到皮肤或眼睛,请反复用水冲洗。 |